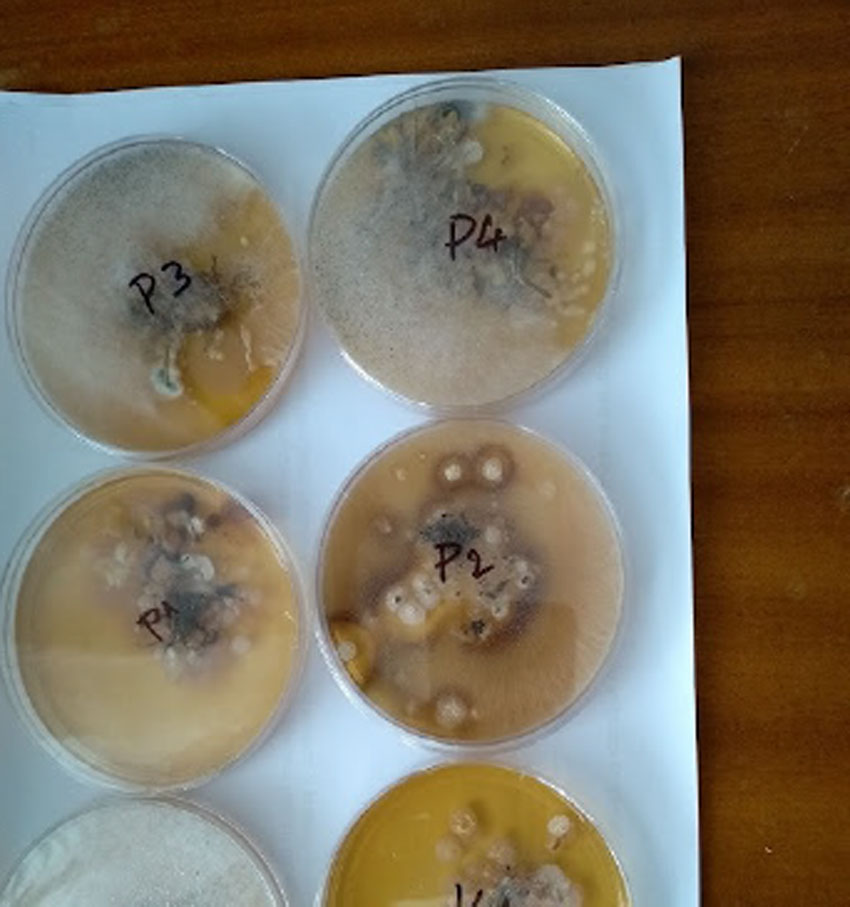
travnik-spartak-trnava--3 travnik-spartak-trnava--3
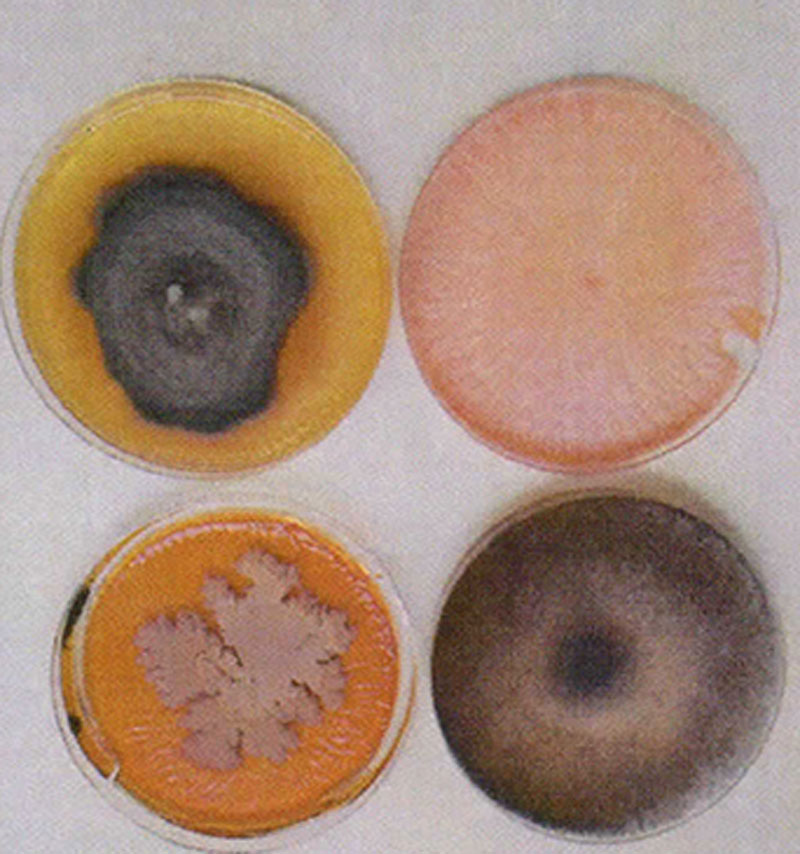
travnik-spartak-trnava--5 travnik-spartak-trnava--5
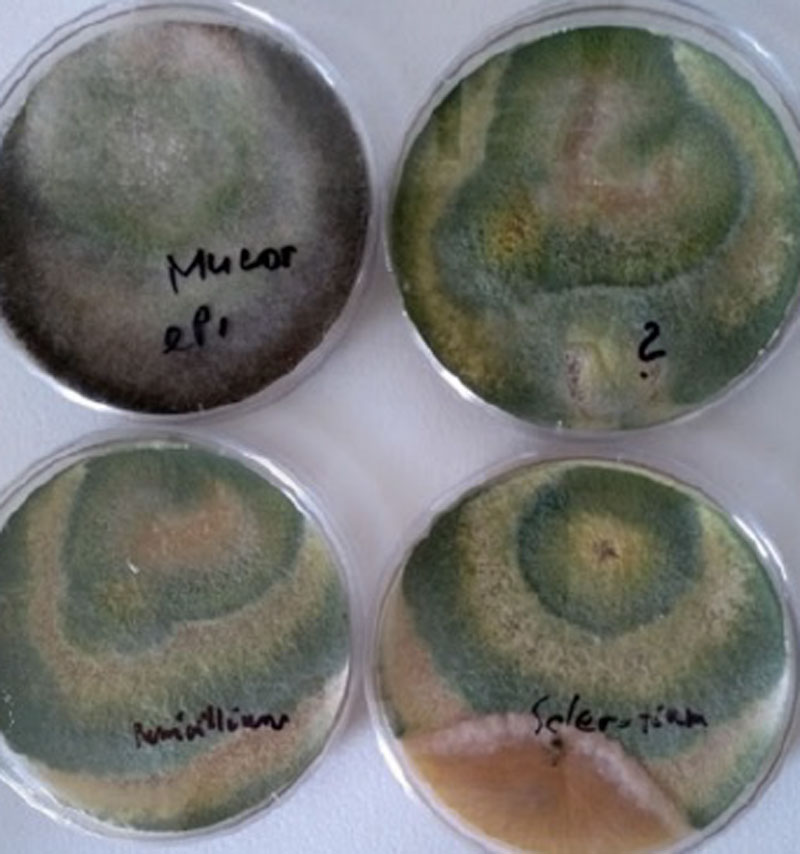
travnik-spartak-trnava--4 travnik-spartak-trnava--4
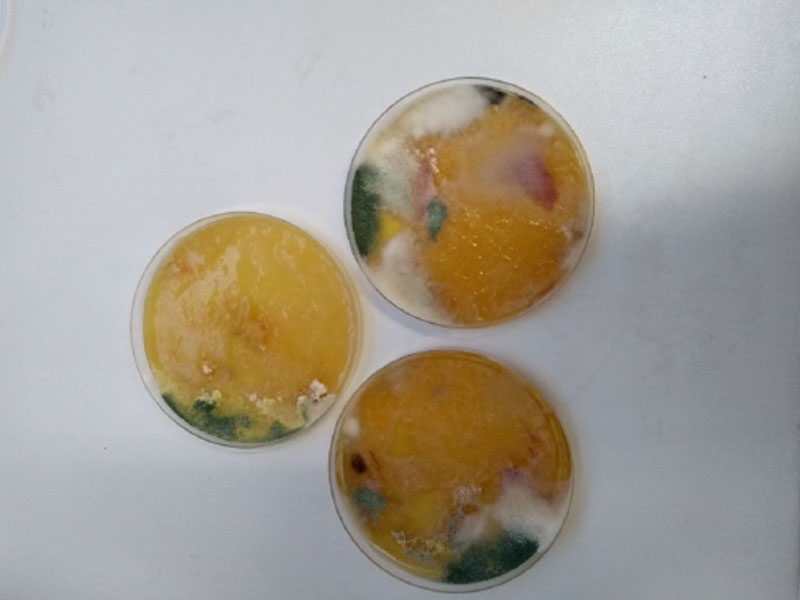
travnik-spartak-trnava--9 travnik-spartak-trnava--9

Vypracoval: doc. Ing. Vladimír Farkaš, DrSc. AZOTER Trading, s.r. o. a Chemický ústav SAV, Bratislava
Dňa 22. 6. 2018 sme vykonali obhliadku trávnika na štadióne Spartaku Trnava v doprovode Ing. Patrika Kováča, správcu trávnika.
Prítomní za AZOTER Trading.s.r.o:
- Ing. Vladimír Farkaš, DrSc. vedecký pracovník Chemického ústavu SAV v Bratislave
- Alena Vymyslická, výrobná manažérka spoločnosti AZOTER Trading, s.r.o.,
- Ing. Ladislav Varga, PhD. z Katedry agrochémie a výživy rastlín Slovenskej poľnohospodárskej univerzity v Nitre a produktový manažér AZOTER Trading s.r.o
- Peter Koller, obchodný zástupca firmy AZOTER Trading, s. r. o.
Cieľom návštevy bolo oboznámenie sa so stavom trávnika a odber vzoriek na mikrobiologický rozbor. Odobrali sa vzorky zo štyroch rôznych miest na ihrisku, ktoré boli najviac potihnuté odumieraním trávnika (stredné pásmo, center, roh, bránkovisko). Typické bolo prerušenie spojenia medzi korienkami a listami rastliniek, ktoré v dôsledku toho odumierali a trávnik vysychal. Komisia konštatovala že pravdepodobnou príčinou zlého stavu trávnika je pravdepodobne fungálna infekcia (Obr. 1).

Obr. 1: Vzhľad trávnika pred sanáciou dňa 18. 8. 2018. Po okrajoch hracej plochy je trávnik umelý.

Obr. 4: Konfrontácia in vitro: jednotlivé izoláty vs. huba Trichoderma. Spóry Trichoderma sú zelené

Obr. 5: Časový priebeh konfrontácie izolátu Sclerotinia vs. Trichoderma, 5. Deň, 10. Deň a 14. deň
Sanácia
Na trávnik (rozloha ca. 1 ha) sa aplikovali postrekom 30 L prípravku AZOTER F , t. j. 3 litre suspenzie konídií TaI2 v koncentrácii 1×109 /ml spolu s 30 litrami pôdnych bakterii v koncentácii 4×109 /ml (Obr. 6).
Prípravok sa nariedil podľa možnosti postrekovača(1:30 až 1:50). Postreky sa opakovali vždy po 14 dňoch. Celkove boli vykonané 4 ošetrenia v 14-dňových intervaloch.
Okrem toho, trávnik bol ošetrený prípravkom na potlačenie nematódov Nematocide a prihnojovaný mikrogranulovaným hnojivom Eaglegreencare.
Skúšky na sladinkovom agare ukázali, že tieto prípravky v koncentráciách 0,1% až 1,5% nemali vplyv na rast huby Trichoderma TaI2.

Obr. 6: Postrek trávnika dávkou 30 litrov AZOTERu F + 3 litre Trichodermi
Kontrola prežívania huby Trichoderma v trávniku
- 09.2018- Týdeň po poslednej aplikácii preparátu Azoter F boli sterilne odobraté vzorky trávnika na mikrobiologickú analýzu výsevom na sladinovom agare (Obr. 7)
- 10.2018- vizuálna kontrola a sterilne odobraté vzorky na mikrobiologickú analýzu (Obr. 8).

Obr. 7: Rozter vzorky pôdy odobratej z trávnika 24.09.2018. Zelená sporulácia indikuje prítomnosť živej huby Trichoderma TaI2.
0br. 8: Roztery vzoriek odobraných z trávnika dňa 23. 9. 2018. Zelená farba konídií indikuje prítomnosť huby Trichoderma. Pozoruhodné je, že rast TaI2 je viditeľný prevažne pri okrajoch misky. Možné vysvetlenie je, že vzorky obsahovali veľké množstvo baktérií Azotobacter a Azospirillum, ktoré na bohatej živnej pôde (sladinkový agar) produkovali hustý viskózny polysacharidový exudát, ktorý bránil prístupu kyslíku a tým znemožňoval rast aeróbnych húb.

Obr. 9: Trávnik pred začiatkom sanácie


(B) po 2 mesiacoch od prvého ošetrenia preparátom Azoter F

Obr. 11: Najviac postihnuté miesta trávnika pred začiatkom sanácie

a po jej ukončeni
Záver
Konštatujeme, že viacnásobné ošetrenie trávnika preparátom Azoter F obsahujúcim baktérie rodov Azotobacter chroococcum a Azospirillum brasiliense a Bacillus megatherium suplementovaným konídiami mykoparazitickej huby Trichoderma atroviride I2 priaznivo pôsobilo na regeneráciu trávnika napadnutého fytopatogénnymi hubami.
Odporúčanie pre budúcnosť: Na intenzívne využívaných trávnych plochách medzi, ktoré nepochybne trávnik futbalového štadiónu Spartaka Trnava patrí okrem využívania všetkých intenzifikačných faktorov (doplnková závlaha, intenzívne hnojenie a výživa, využívanie stimulátorov rastu a pesticídnej ochrany rastlín) má významné miesto aj využitie výživarsko preventívneho resp. ochranárskeho efektu bakteriálneho hnojiva s obsahom mykoparazitickej huby Trichoderma atroviride. Preparát Azoter F odporúčame aplikovať preventívne už pri zakladaní trávnika a potom postrekovať v pravidelných 2-týždňových intervaloch s následným zavlažením trávnika, aby sa postreková tekutina vplyvom závlahy dostala do pôdneho profile. Vzhľadom na zhoršenú intenzitu prúdenia vzduchu na trávniku futbalového ihriska je dôležité racionálne hospodáriť s vodou a s prihnojovacími dávkami, pretože nadmerná vlhkosť a prehnojenie dusíkom resp. nadbytok dusíka v rastlinách, by mohli nepriaznivo vplývať na zdravotný stav trávnika.


